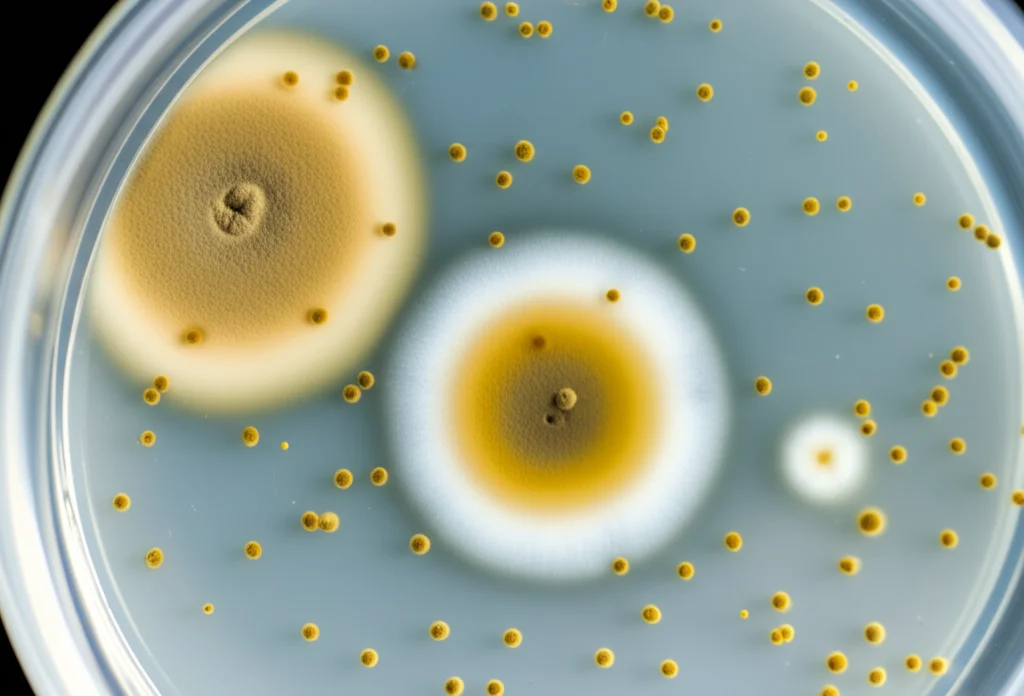
Piastra di Petri con crescita fungina di Aspergillus flavus parzialmente inibita da nanoparticelle di olio di cumino, zona di inibizione visibile, obiettivo macro 60mm, messa a fuoco precisa.

Olio di Cumino Nano-Incapsulato: La Mia Arma Segreta Contro Muffe e Tossine Alimentari!
Ciao a tutti! Oggi voglio parlarvi di qualcosa che mi appassiona tantissimo: come la natura, unita a un pizzico di nanotecnologia, possa aiutarci a rendere il nostro cibo più sicuro. Avete mai pensato a cosa si nasconde, a volte invisibile, nel cibo che mangiamo? Uno dei “cattivi” più noti è un fungo chiamato Aspergillus flavus. Non solo può rovinare i raccolti, ma produce anche una tossina super pericolosa, l’aflatossina B1 (AFB1), che è addirittura cancerogena. Un bel problema, vero? Soprattutto considerando che queste muffe amano cereali, spezie, frutta secca… insomma, un sacco di cose buone!
Da tempo sappiamo che gli oli essenziali, estratti profumatissimi dalle piante, sono ottimi agenti antifungini naturali. Sono classificati come “GRAS” (Generally Recognized as Safe), cioè generalmente sicuri. Tra questi, l’olio essenziale di cumino dei prati (Carum carvi L.), che chiameremo CEO (Caraway Essential Oil), è una vera star: ha proprietà antimicrobiche, antiossidanti e tante altre. Il problema? Gli oli essenziali sono un po’ “timidi”: sono volatili, si degradano facilmente con luce e calore e non amano molto l’acqua. Usarli così come sono nei cibi può essere complicato, anche perché per essere efficaci ne serve parecchio, e questo potrebbe alterare sapore e odore, facendoci storcere il naso.
La Scienza Dietro le Quinte: L’Olio di Cumino e la Nano-Magia
Ed è qui che entra in gioco la scienza, o meglio, la nanotecnologia! E se potessimo “impacchettare” questo potere naturale in minuscole capsule protettive, così piccole da essere invisibili a occhio nudo? L’idea che abbiamo esplorato in questa ricerca è stata proprio questa: usare un polimero naturale, biodegradabile e sicuro come il chitosano (derivato dai gusci dei crostacei, pensate un po’!) per creare delle nanoparticelle capaci di trasportare e proteggere il nostro olio di cumino.
Come abbiamo fatto? Abbiamo usato una tecnica chiamata “gelazione ionica”. Immaginate di creare delle minuscole “sfere” di chitosano (CS) e “intrappolarci” dentro l’olio essenziale (CEO), usando un “collante” sicuro chiamato sodio tripolifosfato (TPP). Il risultato? Delle nanoparticelle caricate con olio di cumino, che abbiamo chiamato CEO-CSNPs.
Ovviamente, non ci siamo fermati qui. Volevamo essere sicuri che il nostro “pacchetto” funzionasse. Abbiamo usato strumenti super tecnologici come il microscopio elettronico a scansione (SEM) per vedere la forma delle nostre nanoparticelle (spoiler: erano belle sferiche!), la DLS (Dynamic Light Scattering) per misurarne le dimensioni (erano davvero nano, sotto i 100 nanometri!) e la spettroscopia FTIR per confermare che l’olio fosse effettivamente intrappolato dentro. Abbiamo anche calcolato quanta percentuale di olio eravamo riusciti a incapsulare (Encapsulation Efficiency – EE) e quanto olio c’era in ogni particella (Loading Capacity – LC). I risultati? Ottimi! L’efficienza di incapsulamento era quasi dell’85%, un successo! Questo significa che il chitosano fa un lavoro eccellente nel proteggere l’olio.

La Prova del Nove: Funghi e Tossine KO!
Ma la vera domanda era: queste nanoparticelle funzionano meglio dell’olio libero? Abbiamo messo alla prova le nostre CEO-CSNPs contro il nemico, l’Aspergillus flavus. Abbiamo usato un metodo classico in laboratorio, il saggio di diffusione su agar. In pratica, abbiamo visto quanto le nostre nanoparticelle riuscivano a bloccare la crescita del fungo su una piastra.
E i risultati? Sorprendenti! L’olio incapsulato ha mostrato un’attività antifungina nettamente superiore rispetto all’olio di cumino libero. Alla concentrazione più alta testata (1000 ppm), la zona di inibizione (l’area dove il fungo non riusciva a crescere) era di ben 35 mm! Ma non è tutto. Abbiamo anche verificato se le nanoparticelle riuscivano a bloccare la produzione della terribile aflatossina B1. Ebbene sì! Le CEO-CSNPs hanno ridotto la produzione di aflatossina del 92.84% in confronto all’olio libero. Un risultato pazzesco! Sembra che l’incapsulamento non solo protegga l’olio, ma ne potenzi anche l’efficacia, forse permettendo un rilascio più controllato e mirato dei suoi componenti attivi direttamente contro il fungo.
Svelare i Segreti Molecolari: Come Funziona?
Ok, funziona alla grande, ma *come* esattamente? Volevamo capirne di più a livello molecolare. Per prima cosa, abbiamo analizzato la composizione chimica del nostro olio di cumino con la gascromatografia-spettrometria di massa (GC-MS). Abbiamo scoperto che i suoi due componenti principali sono il D-Limonene (circa 74%) e il (-)-Carvone (circa 26%). Sono loro i probabili “eroi” della nostra storia.
Poi, siamo andati a “spiare” cosa succedeva a livello genetico nel fungo quando veniva trattato con le nostre nanoparticelle. La produzione di aflatossina è un processo complesso, regolato da specifici geni. Ci siamo concentrati su tre geni chiave: aflR e aflS (che sono come degli interruttori generali) e aflD (coinvolto in uno dei primi passaggi della produzione). Usando una tecnica chiamata qRT-PCR, abbiamo misurato l’espressione di questi geni. Risultato? Sia l’olio libero che, in misura maggiore, quello incapsulato, “abbassavano il volume” di questi geni, ne riducevano significativamente l’espressione. È come se le nostre nanoparticelle dicessero al fungo: “Ehi, smettila di produrre quella roba tossica!”. È interessante notare che le nanoparticelle di solo chitosano (senza olio) non avevano questo effetto, confermando che è proprio l’olio di cumino a fare il lavoro sporco a livello genetico.
E poi, la parte da detective molecolare: il docking molecolare. Abbiamo usato dei modelli computerizzati 3D delle proteine prodotte dai geni aflR, aflS e aflD. Queste proteine sono enzimi cruciali per la produzione della tossina. Abbiamo simulato al computer come i nostri due componenti principali, Carvone e D-Limonene, potessero interagire con queste proteine. È come cercare la chiave giusta (Carvone/Limonene) per bloccare una serratura (le proteine del fungo). E cosa abbiamo scoperto? Che sia il Carvone che il D-Limonene mostravano una forte affinità di legame con queste proteine target, incastrandosi perfettamente nei loro siti attivi. Questo suggerisce che questi composti possono agire come inibitori, bloccando l’attività di questi enzimi e, di conseguenza, fermando la produzione di aflatossina. Fantastico, no?

Cosa Significa Tutto Questo per Noi?
Ma cosa significa tutto questo per la nostra tavola e per l’industria alimentare? Significa che abbiamo tra le mani una potenziale soluzione naturale, ecologica ed efficace per combattere un problema serio come la contaminazione da muffe e aflatossine. Le nanoparticelle di chitosano caricate con olio di cumino (CEO-CSNPs) non solo funzionano meglio dell’olio libero, ma superano anche i suoi limiti pratici (volatilità, stabilità).
Immaginate di poter usare queste bionanocompositi per:
- Proteggere i raccolti di cereali e altri alimenti sensibili.
- Aumentare la durata di conservazione (shelf-life) dei prodotti alimentari.
- Offrire un’alternativa ai conservanti sintetici, che destano sempre più preoccupazioni.
- Sviluppare imballaggi alimentari “attivi” che rilasciano gradualmente l’agente antifungino.
Certo, siamo ancora a livello di ricerca, ma i risultati sono incredibilmente promettenti. Questa tecnologia apre porte davvero interessanti per un futuro con cibo più sicuro e conservato in modo più naturale. È la dimostrazione di come, studiando a fondo la natura e combinandola con tecnologie innovative, possiamo trovare soluzioni brillanti ai problemi che ci affliggono. Io ne sono entusiasta, e voi?
Fonte: Springer
